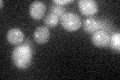
YGR206W
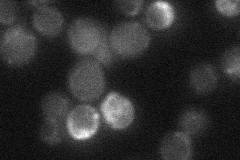
YGR206W
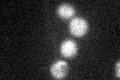
YGR206W

View description
ESCRT-I subunit required to stabilize oligomers of the ESCRT-I core complex (Stp22p, Vps28p, Srn2p), which is involved in ubiquitin-dependent sorting of proteins into the endosome; deletion mutant is sensitive to rapamycin and nystatin
Localization:
Intensity:
Fold change:
Significance:
-
C’ GFP library in SD
punctate22.72 -
N' NOP1pr-GFP in SD

below threshold14.71 -
N' TEF2pr-mCherry in SD

below threshold0 -
N' NATIVEpr-GFP in SD
punctate16.7898 -
N' TEF2pr-VC and Cyto-VN in SD

#N/A0 -
C’ GFP library in SD+DTT

punctate25.911.14No -
C’ GFP library in SD+H2O2
punctate24.091.06No -
C’ GFP library in Starvation Media

punctate29.381.29No -
C’ GFP library on the background of Pup2-DaMP

punctate -
C’ GFP library on the background of CCT mutant

punctate18.50930.814506No
